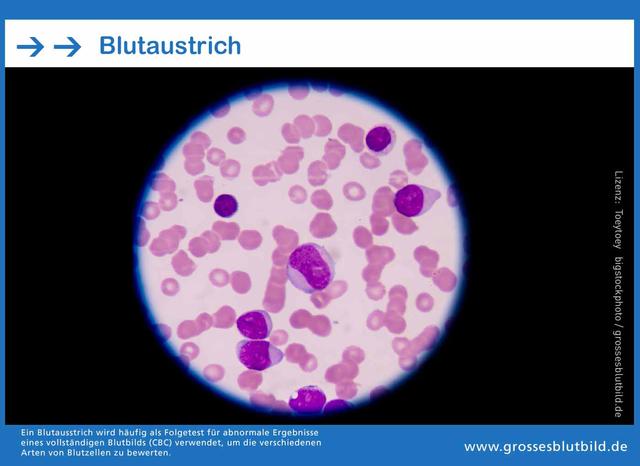
Die Diagnostik des Hämatologen: Wie werden Blut- und Immunerkrankungen festgestellt? Die Diagnostik des Hämatologen: Wie werden Blut- und Immunerkrankungen festgestellt?

Ein Hämatologe ist ein Facharzt, der sich auf die Diagnose und Behandlung von Erkrankungen des Blutes und des blutbildenden Systems spezialisiert hat. Von der Analyse von Blutproben bis zur Durchführung von Chemotherapien gehört es zu den Aufgaben eines Hämatologen, Patienten mit Leukämie, Anämie und anderen Bluterkrankungen zu betreuen. Ihre Expertise ist entscheidend für die frühzeitige Erkennung und effektive Bekämpfung solcher Krankheiten.
- Was bedeutet psychosomatisch? Ursachen, Symptome und Behandlung
- Ideen für originelle Tischkarten selber machen
- Sexsucht oder sinnliche Leidenschaft? Was ist Nymphomanie?
- Beeindruckende Besetzung: Wie in alten Zeiten mit Joaquin Phoenix und Vanessa Kirby
- Einfache Anleitung für die perfekte Käseplatte – in nur 15 Minuten
Die Aufgaben eines Hämatologen: Diagnose und Behandlung von Blutkrankheiten

Ein Hämatologe ist ein Facharzt, der sich auf die Diagnose und Behandlung von Blutkrankheiten spezialisiert hat. Zu den Aufgaben eines Hämatologen gehört es, einfache und komplexe Blutkrankheiten zu diagnostizieren und zu therapieren. Dazu zählen auch Erkrankungen der Blutbildung, der Lymphknoten und des Immunsystems.
Wenn man Fragen oder Beschwerden im Zusammenhang mit dem Blut hat, sollte man sich an einen Hämatologen des MV-Zentrums Am Sachsenring wenden. Dies kann zum Beispiel bei länger andauernden Fieberzuständen ohne eindeutige Erklärung oder bei geschwollenen Lymphknoten, die sich nicht wieder zurückbilden, der Fall sein. Auch Zufallsbefunde beim Hausarzt wie eine Verminderung von roten oder weißen Blutzellen oder eine Vermehrung von Blutzellen können Anlass zur Konsultation eines Hämatologen sein.
Der Hämatologe wird verschiedene Diagnostikverfahren durchführen, um eine genaue Diagnose stellen zu können. Dazu gehören unter anderem eine gründliche Anamnese, bei der auch Vorbefunde des Hausarztes berücksichtigt werden sollten. Eine körperliche Untersuchung sowie Ultraschalluntersuchungen (Sonographie) können ebenfalls zum Einsatz kommen. Die wichtigste Methode zur Diagnostik ist jedoch die Blutabnahme und anschließende Untersuchung im eigenen Labor des MV-Zentrums Am Sachsenring. Hier werden das „kleine Blutbild“ (Anzahl der roten und weißen Blutzellen sowie der Blutplättchen) und das „große Blutbild“ oder „Differentialblutbild“ durchgeführt. Spezialuntersuchungen wie die immunzytologische Spezialdifferenzierung der weißen Blutzellen mittels FACS-Analyse können ebenfalls zum Einsatz kommen.
Im MV-Zentrum Am Sachsenring können alle notwendigen Behandlungsmaßnahmen in der Hämatologie ambulant durchgeführt werden. Dies bietet für den Patienten verschiedene Vorteile, wie zum Beispiel eine schnellere Therapiebeginn, bessere Verträglichkeit der Behandlung und die Möglichkeit, mehr Zeit zu Hause bei der Familie zu verbringen. Nur in wenigen Ausnahmefällen ist ein stationärer Aufenthalt erforderlich. Zu den wichtigsten Behandlungsformen gehören unter anderem Wachstumsfaktoren zur Unterstützung der Blutbildung und unterstützende Therapien zur Vermeidung von Nebenwirkungen.
Die Hämatologen des MV-Zentrums Am Sachsenring arbeiten ganzheitlich für den gesamten Körper, da das Blut für alle Organe und Bereiche des Körpers von großer Bedeutung ist. Daher kooperieren sie eng mit Fachärzten für andere Organsysteme, um eine bestmögliche Versorgung des Patienten sicherzustellen.
Zu den häufigsten Diagnosen in der Hämatologie gehören unter anderem angeborene Blutbildungsstörungen wie die Mittelmeer-Anämie oder die Sichelzellanämie, Anämie durch Eisenmangel oder andere Ursachen, Störungen des Eisenhaushalts wie Eisenmangel oder Hämochromatose, Störungen des Immunsystems durch angeborenen oder erworbenen Mangel an Immunglobulinen, chronische Entzündungsreaktionen, Vermehrung von Immunglobulinen bei MGUS oder Plasmozytom, verminderte Blutzellbildung bei Myelodysplastischem Syndrom oder aplastischer Anämie, vermehrte Blutzellbildung als reaktive Polyglobulie oder eigenständige Erkrankung (Myeloproliferative Neoplasie), Veränderung der Blutbildung bei chronischen Leukämien oder akuten Leukämien sowie Lymphome.
Die Therapie erfolgt in der Regel ambulant durch den vertrauten Hämatologen. Dadurch kann der Patient mehr Zeit zu Hause bei seiner Familie verbringen und Krankenhausaufenthalte mit dem Risiko einer Infektion werden minimiert. In einigen Fällen kann jedoch eine stationäre Therapie erforderlich sein. Bei einer Langzeitbetreuung behält der Patient lebenslang sein vertrautes hämatologisches Team am Sachsenring.
Das MV-Zentrum Am Sachsenring arbeitet mit leistungsfähigen Laboren in ganz Deutschland zusammen, um auch Spezialuntersuchungen durchführen zu können. So kann zum Beispiel bei Verdacht auf eine ernste Störung der Blutbildung eine Knochenmarkpunktion durchgeführt werden.
Die Hämatologie ist ein Fachgebiet, das sich mit der Diagnostik und Therapie von Blutkrankheiten befasst. Ein Hämatologe ist ein Facharzt, der sich auf dieses Gebiet spezialisiert hat und sich mit der Diagnose und Behandlung von Blutkrankheiten beschäftigt.
Welche Rolle spielt ein Hämatologe bei der Diagnostik und Therapie von Bluterkrankungen?

Ein Hämatologe spielt eine entscheidende Rolle bei der Diagnostik und Therapie von Bluterkrankungen. Er ist spezialisiert auf die Untersuchung und Behandlung von Krankheiten, die das Blut, die Blutbildung, die Lymphknoten und das Immunsystem betreffen. Wenn jemand Fragen oder Beschwerden hat, die mit diesen Bereichen zusammenhängen, sollte er sich an einen Hämatologen wenden.
Der Hämatologe wird verschiedene diagnostische Verfahren durchführen, um eine genaue Diagnose zu stellen. Dazu gehört in der Regel eine gründliche Anamnese, bei der der Patient über seine Symptome und Vorerkrankungen berichtet. Es ist auch wichtig, vorhandene Vorbefunde des Hausarztes mitzubringen.
Zusätzlich zur Anamnese wird der Hämatologe eine körperliche Untersuchung durchführen. Oft wird auch ein Ultraschall (Sonographie) eingesetzt, um bestimmte Bereiche genauer zu untersuchen. Eine Blutabnahme ist ebenfalls Teil der Diagnostik. Die Untersuchungen werden im eigenen Labor des hämatologischen Zentrums durchgeführt und können noch am gleichen Tag ausgewertet werden.
Zu den häufigsten Diagnosen gehören unter anderem Anämie (Blutarmut), Störungen des Eisenhaushalts wie Eisenmangel oder Hämochromatose, Störungen des Immunsystems durch angeborenen oder erworbenen Mangel an Immunglobulinen sowie chronische Entzündungsreaktionen.
Das MV-Zentrum für Hämatologie bietet nahezu alle notwendigen Behandlungsmaßnahmen ambulant an. Dies hat für den Patienten einige Vorteile, wie zum Beispiel die Möglichkeit, mehr Zeit zu Hause bei der Familie zu verbringen und das normale Leben weitestgehend beizubehalten. Krankenhausaufenthalte können auf ein Minimum reduziert werden, was auch das Risiko von Krankenhausinfektionen verringert.
Die Therapie erfolgt in enger Zusammenarbeit mit dem vertrauten Hämatologen, der auch die Diagnose gestellt hat. In einigen Fällen kann eine stationäre Therapie notwendig sein, insbesondere bei schweren Komplikationen oder bestimmten Behandlungsverfahren wie Hochdosis-Chemotherapie und Knochenmark-Transplantationen.
Zur Unterstützung der Blutbildung können Wachstumsfaktoren eingesetzt werden, und es stehen auch unterstützende Therapien zur Verfügung, um Nebenwirkungen zu vermeiden.
Das MV-Zentrum für Hämatologie am Sachsenring in Köln bietet eine umfassende Betreuung und Langzeitbetreuung für Patienten mit Bluterkrankungen an. Das Team besteht aus erfahrenen Hämatologen und Krankenschwestern, die den Patienten lebenslang begleiten.
Prof. Dr. med. S. Schmitz
Dr. med. H. T. Steinmetz
Dr. med. J. P. Weber
Dr. med.V.Galkin
MV-Zentrum Sachsenring 69
50677 Köln
Was sind die Tätigkeiten eines Hämatologen im MV-Zentrum Am Sachsenring?

Ein Hämatologe im MV-Zentrum Am Sachsenring befasst sich mit der Diagnostik und Therapie von einfachen und komplexen Blutkrankheiten, der Blutbildung, den Lymphknoten und dem Immunsystem. Sie arbeiten ganzheitlich für den gesamten Körper, da das Blut alle Organe und Bereiche des Körpers versorgt.
Patienten sollten sich bei Fragen oder Beschwerden in Bezug auf Blut- und Immunerkrankungen an einen Hämatologen des MV-Zentrums Am Sachsenring wenden. Häufige Symptome können länger anhaltendes Fieber ohne klare Ursache, geschwollene Lymphknoten, unerklärliche Veränderungen im Blutbild oder chronische Entzündungsreaktionen sein.
Die Diagnostik wird durch eine gründliche Anamnese sowie körperliche Untersuchungen unterstützt. Es werden Blutabnahmen durchgeführt und verschiedene Untersuchungen im eigenen Labor des Zentrums vorgenommen. Dazu gehören das „kleine Blutbild“ zur Bestimmung der Anzahl roter und weißer Blutzellen sowie der Blutplättchen, das „große Blutbild“ oder „Differentialblutbild“ zur Differenzierung der Leukozyten durch eine Fach-MTA (medizinisch-technische Assistentin) sowie immunzytologische Spezialdifferenzierungen der weißen Blutzellen mittels FACS-Analyse.
Bei Verdacht auf ernsthafte Störungen der Blutbildung kann auch eine Knochenmarkpunktion durchgeführt werden. Falls die Ursache für Vergrößerungen von Lymphknoten oder anderen Befunden nicht durch Blutuntersuchungen geklärt werden kann, kann der Hämatologe bei der Auswahl des optimalen Chirurgen für eine Probeentnahme beratend tätig sein.
Im MV-Zentrum Am Sachsenring können nahezu alle notwendigen Behandlungsmaßnahmen ambulant und mit optimaler Qualität durchgeführt werden. Die wichtigsten Behandlungsformen umfassen unter anderem Wachstumsfaktoren zur Unterstützung der Blutbildung sowie unterstützende Therapien zur Vermeidung von Nebenwirkungen.
Durch die ambulante Therapie kann der Patient mehr Zeit zu Hause mit seiner Familie verbringen und Krankenhausaufenthalte mit dem Risiko von Infektionen auf ein Minimum reduziert werden. Stationäre Therapien sind heute nur noch bei schwerwiegenden Komplikationen oder Hochdosis-Chemotherapie und Knochenmark-Transplantationen erforderlich. Bei einer Langzeitbetreuung behält der Patient lebenslang sein vertrautes hämatologisches Team am Sachsenring, bestehend aus Hämatologe und Krankenschwestern.
Die Hämatologen im MV-Zentrum Am Sachsenring haben enge Kooperationen mit Fachärzten für andere Organsysteme aufgebaut, da Bluterkrankungen auch andere Organe beeinträchtigen können und Erkrankungen anderer Organe zu Veränderungen im Blut führen können.
Prof. Dr. med. S. Schmitz
Dr. med. H.T. Steinmetz
Dr. med. J.P. Weber
Dr. med. V. Galkin
MV-Zentrum Sachsenring 69
50677 Köln
Die ganzheitliche Arbeitsweise eines Hämatologen im MV-Zentrum Am Sachsenring

Ein Hämatologe im MV-Zentrum Am Sachsenring arbeitet ganzheitlich und betrachtet den gesamten Körper, da das Blut für alle Organe und Bereiche des Körpers wichtig ist. Daher können sämtliche Diagnosen aus dem Bereich der Blut- und Immunerkrankungen durch eine ambulante Diagnostik sicher und schnell gestellt werden. Oftmals kann nach kurzer Zeit Entwarnung gegeben werden, wenn sich Verdachtsmomente als harmlos erweisen oder Veränderungen von selbst zurückbilden.
Um eine genaue Diagnose zu stellen, führt der Hämatologe verschiedene Untersuchungen durch. Zunächst erfolgt eine gründliche Anamnese, bei der auch Vorbefunde des Hausarztes berücksichtigt werden sollten. Anschließend folgt eine körperliche Untersuchung, bei Bedarf wird auch eine Ultraschalluntersuchung (Sonographie) durchgeführt. Eine Blutabnahme ist ebenfalls Teil der Diagnostik.
Im eigenen Labor des MV-Zentrums werden die Blutproben untersucht. Dabei werden unter anderem ein „kleines Blutbild“ erstellt, bei dem die Anzahl der roten und weißen Blutzellen sowie der Blutplättchen bestimmt wird. Ein „großes Blutbild“ oder „Differentialblutbild“ ermöglicht die Differenzierung der Leukozyten durch mikroskopische Untersuchung eines Blutausstriches. Zudem kann mittels einer immunzytologischen Spezialdifferenzierung die Zusammensetzung der weißen Blutzellen bestimmt werden.
Für spezielle Untersuchungen kooperiert das MV-Zentrum mit leistungsfähigen Laboren in ganz Deutschland. Bei Verdacht auf eine ernsthafte Störung der Blutbildung kann auch eine Knochenmarkpunktion durchgeführt werden, deren Ergebnisse im eigenen Labor ausgewertet werden. Dadurch kann beispielsweise noch am gleichen Tag eine lebensbedrohliche akute Leukämie ausgeschlossen werden.
Wenn die Ursache für Veränderungen nicht durch die Blutuntersuchung geklärt werden kann, berät der Hämatologe bei der Auswahl des optimalen Chirurgen für eine Probeentnahme von Lymphknoten oder anderen Befunden.
Die Hämatologen im MV-Zentrum Am Sachsenring arbeiten eng mit Fachärzten anderer Organsysteme zusammen, da Bluterkrankungen alle Organe beeinträchtigen können und Erkrankungen anderer Organe zu Veränderungen des Blutes führen können.
Zu den häufigsten Diagnosen gehören unter anderem angeborene Blutbildungsstörungen wie die „Mittelmeer-Anämie“ (Thalassämie) oder Sichelzellanämie, Anämie (Blutarmut) durch Eisenmangel oder andere Ursachen, Störungen des Eisenhaushalts wie Eisenmangel oder Hämochromatose, Störungen des Immunsystems durch Mangel an Immunglobulinen, chronische Entzündungsreaktionen sowie verschiedene Formen von Verminderung oder Vermehrung von Blutzellen.
Im MV-Zentrum können nahezu alle notwendigen Behandlungsmaßnahmen ambulant durchgeführt werden. Dies hat für den Patienten mehrere Vorteile, wie zum Beispiel die Möglichkeit, mehr Zeit zu Hause bei der Familie zu verbringen und eine bessere Verträglichkeit der Behandlungen, da das normale Leben weitestgehend erhalten bleibt. Krankenhausaufenthalte können auf ein Minimum reduziert werden.
Zu den wichtigsten Behandlungsformen gehören unter anderem die Gabe von Wachstumsfaktoren zur Unterstützung der Blutbildung sowie unterstützende Therapien zur Vermeidung von Nebenwirkungen.
Die Therapie erfolgt in der Regel durch den vertrauten Hämatologen, der auch die Diagnose gestellt hat. Stationäre Aufenthalte sind heutzutage nur noch bei schweren Komplikationen oder bestimmten Behandlungsmaßnahmen notwendig. Bei einer Langzeitbetreuung behält der Patient lebenslang sein vertrautes hämatologisches Team am Sachsenring (Hämatologe und Krankenschwestern).
Welche Fragen und Beschwerden sollte man an einen Hämatologen richten?

Fragen:
– Welche Blutkrankheiten können diagnostiziert und behandelt werden?
– Welche Untersuchungen und Tests sind notwendig, um eine genaue Diagnose zu stellen?
– Welche Behandlungsmöglichkeiten stehen zur Verfügung?
– Wie lange dauert die Behandlung in der Regel?
– Gibt es alternative Therapien oder klinische Studien, an denen man teilnehmen kann?
Beschwerden:
– Lang anhaltendes Fieber ohne erkennbare Ursache
– Geschwollene Lymphknoten, die sich nicht zurückbilden
– Verminderung von Blutzellen (Anämie)
– Vermehrung von Blutzellen (Polyglobulie, Thrombozytose)
– Chronische Entzündungsreaktionen (erhöhte Blutsenkungsgeschwindigkeit oder C-reaktives Protein)
– Abweichungen bei den Bluteiweißen
– Störungen des Eisenhaushalts
– Probleme mit dem Immunsystem
Diese Liste ist nicht abschließend. Es ist wichtig, jegliche Fragen oder Beschwerden mit einem Hämatologen zu besprechen, um eine genaue Diagnose und angemessene Behandlung zu erhalten.
Die Diagnostik des Hämatologen: Wie werden Blut- und Immunerkrankungen festgestellt?
Der Hämatologe führt eine gründliche Anamnese durch und berücksichtigt dabei auch die Vorbefunde des Hausarztes. Eine körperliche Untersuchung sowie eine Ultraschalluntersuchung (Sonographie) können ebenfalls Teil der Diagnostik sein. Zudem wird eine Blutabnahme durchgeführt, um verschiedene Untersuchungen im eigenen Labor durchführen zu können.
Im Labor werden das „kleine Blutbild“ (Anzahl der roten, weißen Blutzellen und Blutplättchen), das „große Blutbild“ oder „Differentialblutbild“ (mikroskopische Untersuchung eines Blutausstriches zur Differenzierung der Leukozyten) sowie die immunzytologische Spezialdifferenzierung der weißen Blutzellen mittels FACS-Analyse durchgeführt. Für spezielle Untersuchungen arbeitet das MV-Zentrum mit leistungsfähigen Laboren in ganz Deutschland zusammen.
Bei Verdacht auf eine ernste Störung der Blutbildung kann eine Knochenmarkpunktion durchgeführt werden, deren Ergebnisse ebenfalls im eigenen Labor ausgewertet werden können. Dadurch kann zum Beispiel noch am gleichen Tag der Verdacht auf eine lebensbedrohende akute Leukämie ausgeschlossen werden.
Falls die Ursache für Veränderungen wie vergrößerte Lymphknoten nicht durch die Blutuntersuchung geklärt werden kann, kann der Hämatologe bei der Auswahl des optimalen Chirurgen für eine Probeentnahme beratend tätig werden.
Die enge Kooperation des MV-Zentrums für Hämatologie mit Fachärzten für andere Organsysteme ermöglicht eine ganzheitliche Betreuung, da Bluterkrankungen alle Organe beeinträchtigen können und Erkrankungen anderer Organe zu Veränderungen im Blut führen können.
Ein Hämatologe ist ein Facharzt, der sich auf die Diagnose und Behandlung von Blutkrankheiten spezialisiert hat. Zu seinen Aufgaben gehört die Untersuchung des Blutes, um Krankheiten wie Leukämie, Anämie oder Gerinnungsstörungen zu erkennen. Durch die enge Zusammenarbeit mit anderen medizinischen Fachgebieten spielt der Hämatologe eine wichtige Rolle in der ganzheitlichen Patientenversorgung.

